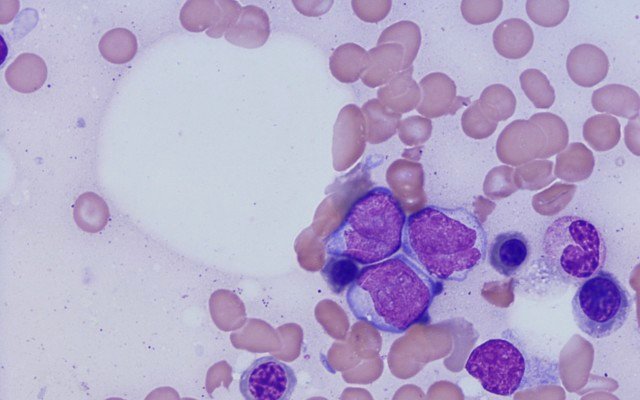
Prescient Therapeutics expands study after completely eradicating cancer in patients

Cancer drug developer Prescient Therapeutics (ASX: PTX) is expanding its Phase 1b study in patients with acute myeloid leukemia (AML) after three patients were completely eradicated of the disease.
The clinical stage company had been treating a total of 15 patients with relapsed or refractory AML with its novel drug PTX-200.
Relapsed or refractory cancers are generally difficult to treat as it means the cancer is resistant and doesn’t respond effectively to treatment.
In today’s announcement, Prescient confirmed that three of the patients had experienced complete responses in the study, meaning their cancer has been totally eradicated.
These three patients were receiving 25-35 milligrams per square metre of PTX-200 together with 200-400mg/m2 of the chemotherapy agent cytarabine.
Prescient chief medical officer Dr Terrence Chew said the three complete responses are “very encouraging in a hard-to-treat patient population”.
Changes to dosing schedule in study expansion
After consulting with study investigators, Prescient said it will make a protocol amendment to change the dosing schedule of PTX-200 in relation to the administration of cytabarine, with the aim of minimising overlapping drug interactions.
A previous Phase 1b study in acute leukemias using PTX-200 as a single agent, where no particular side effects were observed, could suggest that the effects seen in the current study may be due to the overlapping interaction of the chemotherapy agent and PTX-200.
According to Prescient, most patients receiving treatment on the study by group have tolerated planned dose levels.
The company said the amendment will go through the usual FDA and ethics committee reviews and the study “should be able to re-start enrolment in early 2020”.
“Through this protocol amendment, we aim to get more patients through more cycles of therapy, with the hope of expanding upon these responses,” Dr Chew said.
“Our investigators are very supportive of these amendments, as they are encouraged by these results in a patient population that is very difficult to treat and who currently have few treatment options,” he added.
PTX-200
PTX-200 is a novel PH domain inhibitor that inhibits an important tumour survival pathway known as Akt. This pathway plays a key role in the development of cancers including leukemia, breast and ovarian cancer.
According to Prescient, PTX-200 differs from other Akt-inhibiting drug candidates, which can have toxicity problems, by being comparatively safer.
The Phase 1b study on AML patients is being led by leukemia expert Professor Jeffrey Lancet at the H. Lee Moffitt Cancer Centre in Florida, US, with the involvement of the Kansas University Medical Centre and the Yale Cancer Centre.
PTX-200 is also currently being examined in a Phase 2 study in breast cancer patients and in a Phase 1b trial in patients with recurrent or persistent platinum resistant ovarian cancer.
In other news, Prescient announced last week it had entered into a collaboration in Australia with Adelaide-based Carina Biotech to develop new Chimeric Antigen Receptor T-cell (CAR-T) targeted cell therapies for cancer patients with solid tumours.
Prescient shares had climbed 46.67% on the news to $0.11 by early afternoon trade.